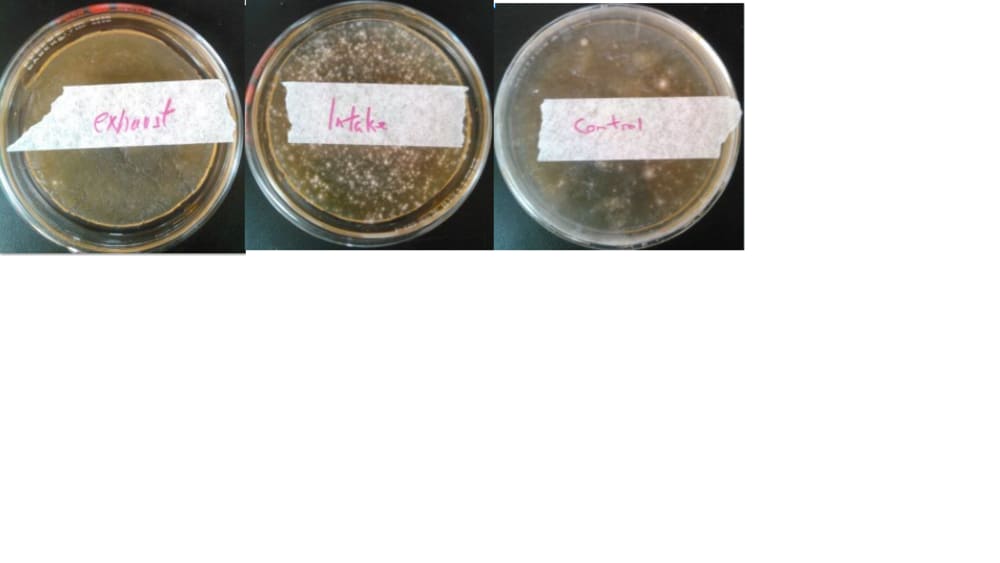

I have designed an UVC air filter that actively sterilizes the air without the need to evacuate the room. It involves a duct fan which draws air through a physical filter on the intake at the bottom. The filter eliminates dust. This increases the efficiency of the UVC sterilization. The air then flows past two 4 foot UVC florescent lights mounted on the interior of a 5 foot 8 inch diameter duct. The lights are mounted 2 inches from the duct wall. The air is in the presence of the UVC light for a period of about 4 - 5 seconds at a max distance of around 3 inches. Literature suggests this is a satisfactory time to sterilize live particles passing through.
The overall flow rate of the air is such that the volume of air in my classroom is cycled through the sterilizers approximately every 20 minutes. Meaning the air is my room is, ideally, sterilized 3 times every class.
Testing with agar plates showed a significant decrease in the number of mold and fungus populations. While this does not imply that the filter kills virus particles it is encouraging. The mode of sterilization is the same.
Like this entry?
-
About the Entrant
- Name:Pat Blount
- Type of entry:individual
- Patent status:none